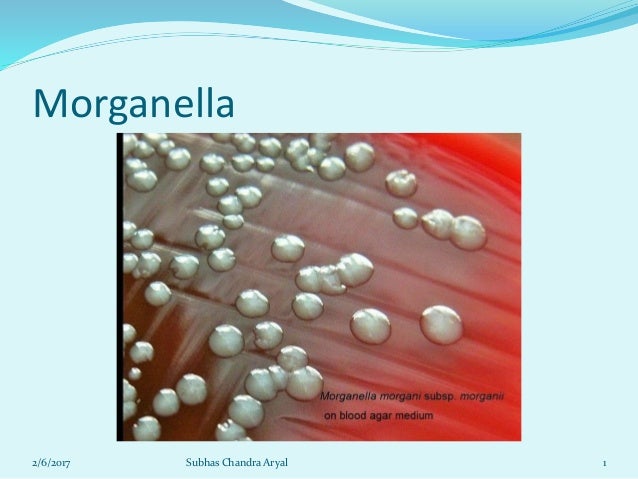

Eosin Methylene Blue Agar Emb Is Useful To Isolate And Identify Organisms Likely To Cause

Eosin Methylene Blue Emb Agar Principle Purpose And

Jmorata Types Of Agar

Salmonella Shigella Agar Ss Pdf Document


Embagar Instagram Posts Photos And Videos Instazu Com

I Ve Attached Lab Worksheets And Images Phenylet

Cultivation Media For Bacteria
About Morganella Species

Ex 11 Isolation Of Stool Flora Flashcards Quizlet

Macconkey Eosin Methylene Blue Dipslide Precision Laboratories

Embagar Instagram Photo And Video On Instagram
Tidak ada komentar untuk "Eosin Methylene Blue Agar Emb Is Useful To Isolate And Identify Organisms Likely To Cause"
Posting Komentar